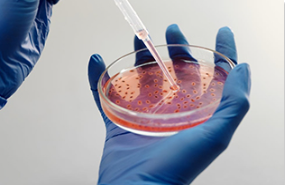

联系人:张工
联系方式:18953207190
400 电话:400-883-6263
地址:浙江省杭州市上城区九堡街道鑫运时代金座1幢319室A38
德信标质检测(杭州)有限公司是一家专业提供轨道交通、防火阻燃、汽车零部件、橡胶、塑料、电线电缆、高分子材料、航空航天、金属、化工等领域检测分析服务的综合型技术服务企业。总部位于青岛,拥有数百台完备、先进的材料测试仪器设备和专业的技术专家团队,拥有多个实验基地。先后获得特种设备检测 CASEI、CMA等检测资质,是为各企事业单位量身提供检验检测、咨询鉴定、质量控制等综合服务的第三方检测机构。